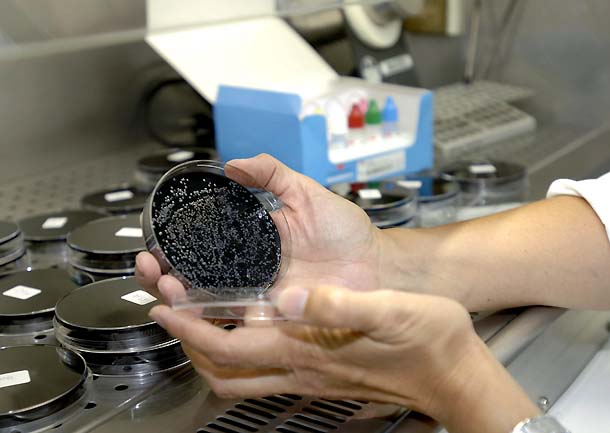

El término legionela, nombre de la enfermedad también conocida como legionelosis o enfermedad del legionario, se escribe en español con una sola ele en la última sílaba y no con dos, y en minúscula.
Con motivo del brote de esta enfermedad en Sabadell, en los medios de comunicación puede verse la grafía legionella, con ll, por influencia del nombre científico de las bacterias que la causan: «Dos personas mueren tras enfermar de legionella» o «Dos personas han fallecido y 20 se encuentran afectadas por un brote de legionella en Sabadell», donde lo adecuado habría sido escribir legionela.
El uso ha hecho que la palabra legionela no solo sea el nombre común de la bacteria, que pertenece al género con denominación científica Legionella (en cursiva, mayúscula y, entonces sí, con elle), sino también el de la enfermedad, tal y como se recoge en el Diccionario de la Academia y en su Diccionario del estudiante. Es decir, en medios no especializados, es igualmente correcto llamar legionela, legionelosis o enfermedad del legionario a esta enfermedad.
No obstante, conforme al Diccionario de términos médicos, de la Real Academia Nacional de Medicina, en textos médicos lo apropiado es mantener la distinción tradicional entre la bacteria (legionela) y la enfermedad (legionelosis neumónica o enfermedad del legionario).